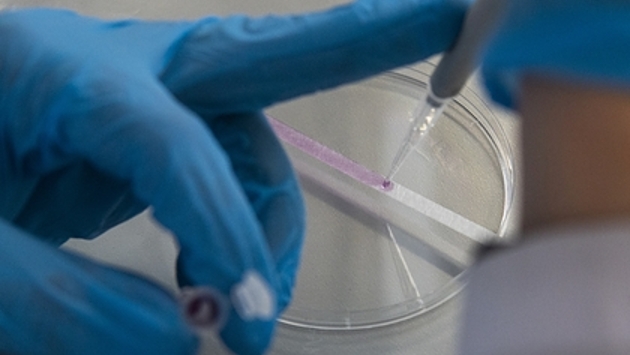

Одно конкретное лекарство, которое будет способно победить новую коронавирусную инфекцию, вряд ли будет создано. Об этом РИА Новости заявил председатель фонда «Сколково» Аркадий Дворкович.
Он пояснил, что болезнь связана с иммунной системой, и, вероятнее всего, для лечения будет подбираться набор разных лекарств и методов профилактики, лечения и восстановления, а не «волшебный препарат, который все вылечит». Чиновник добавил, что во всем мире ведутся поиски лекарства, но цикл разработки таких препаратов довольно длинный из-за постоянно мутирующего вируса, и «ждать чудес» не стоит.
Ранее вирусолог, доктор биологических наук Александр Шестопалов высказал противоположную точку зрения. По его словам, препарат, который позволит защитить от всех штаммов COVID-19, может появиться за шесть месяцев или за год. «Американские ученые, конечно, молодцы. Но активные работы ведут и их российские коллеги. В частности, в Институте цитологии и генетики Сибирского отделения Академии наук тоже работают над такими антителами, причем с успехом», — резюмировал эксперт.
2 сентября врач и телеведущая Елена Малышева перечислила препараты, которые используются при лечении COVID-19, указанные на сайте Национальных институтов здоровья США. По словам доктора, доказано, что все они помогают в борьбе с инфекцией. Основными препаратами для лечения больных она назвала антикоагулянты. «Глобально два основных лекарства: это "Ксарелто" и "Эликвис". И препарат основной инъекционный — это "Клексан"», — сказала медик. Вторым препаратом для эффективного лечения COVID-19 врач назвала «Дексаметазон». Его запрещено назначать амбулаторно, к тому же Малышева не рекомендует принимать его без предписания доктора. Отдельное внимание Малышева уделила моноклональным антителам: лекарствам «Актемра» и «Олумиант», которые оба доказали свою эффективность.